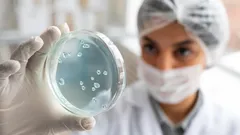
Vuosisadan huijaus: tämä bakteeri teeskentelee kuollutta selviytyäkseen vaikeissa olosuhteissa

503
2
4 minuuttia
Suositellut artikkelit

Vuosisadan huijaus: tämä bakteeri teeskentelee kuollutta selviytyäkseen vaikeissa olosuhteissa
Tersicoccus phoenicis – hämmästyttävä avaruusmikrobi, joka selviää lepotilassa jopa tiukoista steriloinneista. Näin se piiloutuu, herää ja miksi sillä on väliä myös täällä.

Mitkä säännölliset liikuntamuodot vahvistavat immuunijärjestelmää – opas aloittelijoille ja ikääntyville
Aktiivinen elämäntapa ja urheilu

Etkö petaa sänkyäsi aamuisin? Psykologit paljastavat, mitä se kertoo persoonallisuudestasi
Arjen käytännöt

10 minuutin päivittäiset harjoitukset vastustuskyvyn parantamiseen – helpot keinot terveelliseen syksyyn
Aktiivinen elämäntapa ja urheilu

Ei tarvitse kävellä 10 000 askelta: Näin ikäihmiset voivat helposti parantaa muistiaan kävelemällä
Aktiivinen elämäntapa ja urheilu

Unohda kaurapuuro: näin sata vuotta elävät ihmiset aloittavat aamunsa – ikuisen nuoruuden resepti
Terveellinen ravinto

14 pitkän iän salaisuutta maailman vanhimmilta ihmisiltä: Mitä neuvoja he antavat?
Terveellinen ravinto

Laihdu kotona 30 päivässä helposti: asiantuntijoiden treenisuunnitelma ilman kuntosalia
Aktiivinen elämäntapa ja urheilu

Litteä vatsa ilman lankkuja ja vatsarutistuksia: 6 harjoitusta, jotka toimivat myös väsymyksen hetkellä
Aktiivinen elämäntapa ja urheilu

Nelikulmainen hengitys ja jooganiidra – tehokkaimmat tavat ladata päiväsi uudelleen
Mielenterveys

Tasapaino yli 50-vuotiaille: Harjoitusohjelma tasapainon vahvistamiseen ja kaatumisten ehkäisyyn
Aktiivinen elämäntapa ja urheilu
Vuosisadan huijaus: tämä bakteeri teeskentelee kuollutta selviytyäkseen vaikeissa olosuhteissa
Yhteiskunnan ilmiöt

Mitä näit kuvassa ensimmäisenä? Psykologinen testi, joka paljastaa piilevät persoonallisuuden piirteet
Mielenterveys

Tutkijoiden salaisuus: näin keität pastan oikeasti oikein – tieteellisesti oikea tapa
Mielenterveys

Tämä yksinkertainen ainesosa suojaa vedenkeitintäsi kalkilta – käytä sitä ennen veden kiehauttamista
Arjen käytännöt

Heitätkö jatkuvasti avokadon kivet pois? Tässä on, mitä niillä voi tehdä kahdessa minuutissa
Arjen käytännöt

Homeen poisto silikonisaumoista pesualtaan ympäriltä – yksinkertainen keino ilman ammattilaista
Arjen käytännöt
 Julkaisu Virta
Julkaisu Virta

Kommentit